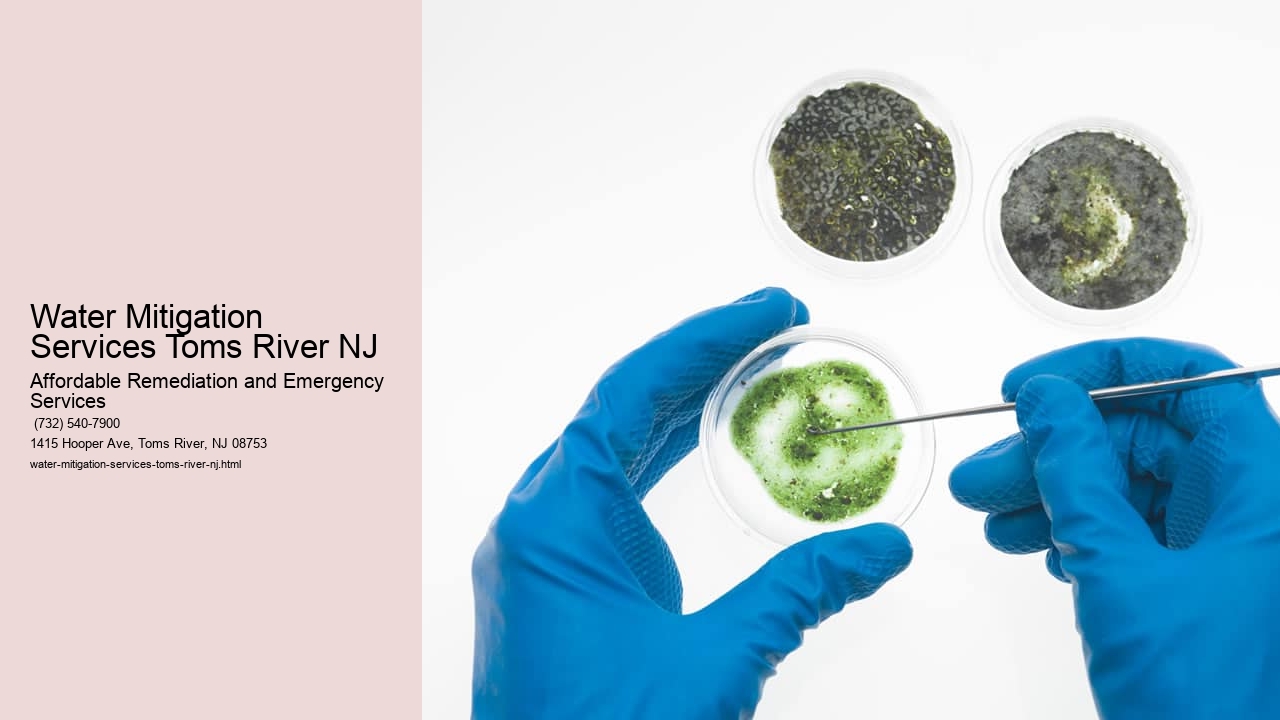

Affordable Remediation and Emergency Services, established in 2008, is Toms River, NJ's premier choice for mold removal, mold remediation, and biohazard cleaning. Our licensed and trained certified experts provide 24/7 emergency biohazard cleanup and testing services, guaranteeing safe handling of any crime scene, flood, or black mold cleaning.
Affordable Remediation and Emergency Services
1415 Hooper Ave, Toms River, NJ 08753, United States
(732) 540-7900
Mold infestation can be a homeowner's nightmare, particularly in areas like Toms River, NJ, where humidity and moisture can contribute to its proliferation. Dealing with mold cleanup requires not just effort but also knowledge to ensure the process is both effective and safe. Here are four expert tips that might seem counterintuitive at first but are crucial for tackling mold issues in your home.
Firstly, when discovering mold in your house, your instinct might be to immediately scrub it away. However, this approach could inadvertently spread spores throughout your home. Instead of hastily scrubbing, take a moment to assess the situation calmly. Determine the extent of the mold and consider if it's something you can handle yourself or if professional help is necessary.
Secondly, people often reach for bleach as their go-to mold killer. However, bleach isn't always the best solution for all types of mold or surfaces. It may be effective on non-porous materials but can fail to penetrate porous surfaces where mold roots deeply reside. Therefore, using a product specifically designed for killing mold is more advisable than reaching for potentially ineffective bleach.
Thirdly, another common misconception is that once you've cleaned the visible mold, your job is done. In reality, visible mold may just be the tip of an iceberg; there could be more lurking behind walls or under floors. After cleaning up any apparent growths, investigate further to ensure there are no hidden colonies elsewhere in your home.
Lastly, while focusing on removing existing mold is essential, prevention should also be part of your strategy. Simply put: address the underlying causes such as leaks or high humidity levels to prevent future growths from occurring after cleanup efforts are completed.
These four pieces of advice aren't typically what one would expect when contemplating DIY approaches to managing household mold problems. Nevertheless, they provide critical insights into performing an efficient and thorough cleanup operation within homes situated in places like Toms River where environmental conditions can often foster fungal outbreaks.
By incorporating these seemingly unlikely steps into your remediation plan – pausing before action; choosing appropriate chemicals; digging deeper than surface level; and emphasizing preventive measures – you stand a better chance at not only eradicating current manifestations but also safeguarding against potential future infestations of unwelcome molds in your New Jersey residence.
View Home Mold Remediation Toms River NJ in a full screen map
| Entity | Definition |
|---|---|
| Toms River, NJ | A township in Ocean County, New Jersey, USA, where the company provides mold and water damage services. |
| Ocean County, NJ | A county in New Jersey, USA, where the company offers mold remediation and restoration services. |
| Monmouth County, NJ | A county in New Jersey, USA, where the company serves clients with mold testing and cleanup services. |
| Wall Township, NJ | A township in Monmouth County, New Jersey, USA, where the company provides mold and water damage restoration. |
| Freehold, NJ | A borough in Monmouth County, New Jersey, USA, where the company offers mold testing and remediation services. |
| Lacey Township, NJ | A township in Ocean County, New Jersey, USA, where the company provides mold and water damage restoration. |
| Jackson Township, NJ | A township in Ocean County, New Jersey, USA, where the company offers mold testing and remediation services. |
Exploring mold removal solutions in Toms River, New Jersey can be a daunting task for homeowners faced with this pesky problem. Mold is not only unsightly but also poses serious health risks, making it imperative to address promptly and effectively. With numerous companies offering remediation services, it's crucial to discern which provide the best value and results.
When embarking on your quest for a reputable mold removal company, consider several key factors: expertise, certification, methods used, customer reviews, cost estimates, and guarantees offered. By meticulously comparing these aspects across different providers, you'll ensure that you select a service that meets your specific needs while delivering high-quality workmanship.
Firstly, professional experience plays a pivotal role. Look for companies with a track record of successfully handling various types of mold infestations. Such seasoned businesses are likely more adept at identifying the root causes of mold growth and eradicating it thoroughly.
Certifications are another essential consideration. Reputable firms should have industry-recognized credentials from organizations like the Institute of Inspection Cleaning and Restoration Certification (IICRC). These attest to their adherence to strict standards and proficiency in mold remediation techniques.
Furthermore, scrutinize the methods each company employs. The least effective approaches might involve mere surface cleaning or painting over affected areas—inefficient tactics that fail to eliminate underlying issues. Conversely, proficient contractors will use advanced technology such as HEPA air filtration systems and antimicrobial treatments to remove spores comprehensively.
Customer reviews offer invaluable insight into real-world experiences with these services. While some feedback might be overwhelmingly positive or negative outliers, overall trends can highlight consistent quality or recurrent problems within an organization's operations.
Also important is obtaining detailed cost estimates before committing to any service provider. This transparency enables comparison shopping without unexpected expenses later on in the project timeline; however, remember that cheaper isn't always better when dealing with something as critical as mold removal.
Lastly, consider whether companies provide guarantees or warranties post-remediation. Those willing to stand by their work typically exude confidence in their ability to deliver lasting solutions—a reassuring sign for any homeowner seeking peace of mind after the job is done.
In conclusion, selecting among Toms River's array of mold removal companies requires diligent research and careful evaluation based on multiple criteria. By taking the time to weigh these factors against one another through comprehensive analysis rather than leapfrogging hastily toward decisions based solely on price or cursory information could make all the difference between temporary relief and long-term resolution concerning household mold problems.

We serve a wide range of areas in New Jersey including Toms River, Ocean County, Wall Township, Freehold, Lacey Township, Ocean Township, Middlesex, Monmouth County, Jackson Township, Barnegat Township, Farmingdale, and Manchester Township.
We prioritize customer satisfaction by providing honest, reliable, and efficient services backed by our experienced professionals and industry-leading techniques.
Affordable Remediation and Emergency Services offers a comprehensive range of services including mold testing, sewage cleanup, water damage restoration, water mitigation, mold removal, and water extraction.
Yes, in addition to mold removal, we also provide services such as sewage cleanup, water damage restoration, water mitigation, and water extraction to address various emergency situations. |
If you suspect mold growth in your property, it's crucial to contact us immediately for a thorough inspection and prompt remediation to prevent further damage and health risks.